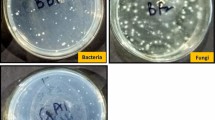

Abstract
Zinc oxide nanoparticles (ZnONP) were synthesized and characterized using SEM, EDAX, DLS and UV–Vis spectra. Its use as a nanofertilizer as an alternative to conventional zinc sulphate (ZnSO4.7H2O) was evaluated in five Zn-deficient soils with a variable pH range (7.2–8.7). For this, the carbon of the soil microbial biomass (SMBC), the bacterial population, the nutrient dynamics and the biometric parameters of the wheat crop were assessed. The varying dosages (0, 100, 200 and 500 mg/L), sizes (30–100 nm), and the spherical shape of ZnONPs were evaluated in comparison to ZnSO4.7H2O levels. Results showed the maximum SMBC and bacterial population at 100 mg/L of ZnONPs but a sharp decline at higher concentrations. In addition, soil application of ZnONPs at 5 mg/kg produced a higher root elongation (4.3–8.8%), shoot elongation (3.5–4.0%), total chlorophyll (4.9–5.6%), grain yield (1.7–2.3%) and grain Zn-content (1.6–2.1%) in comparison to the conventional ZnSO4.7H2O at 10 mg/L. ZnONPs at 100 mg/L produced a higher soil microbial biomass carbon (3.9–4.6%), bacterial population (7.2–9.0%), germination (22%) and grain Zn-content (17.9–20%) as compared to the conventional ZnSO4.7H2O at 0.5%. The higher grain Zn-contents could be attributed to the small size and high surface area of ZnONPs resulting in easy entry into the plant system either through root or foliar by penetrating the pores present in the cell membranes. Conversely, the conventional ZnSO4.7H2O, due to its larger size and higher solubility as compared to ZnONPs, has low retention in plant systems, high surface run-off and low fertilizer efficiency. Thus, the authors concluded to apply spherically synthesized ZnONPs (average size-36.7 nm) at 5 mg/kg in the soil application and 100 mg/L in the foliar application for maintaining SMBC and bacterial population, improving total chlorophyll, and grain Zn-contents and overall sustaining wheat production in Zn-deficient neutral and alkaline soils.
Similar content being viewed by others
Explore related subjects
Discover the latest articles, news and stories from top researchers in related subjects.Avoid common mistakes on your manuscript.
Introduction
Wheat (Triticum aestivum L.) is an important cereal crop and the second major caloric source after rice. It is the basic and nutritious staple food of the world. However, due to an imbalance in the 6Ps (population, poverty, pollution, precipitation, periodicity and plantation) and/or an increase in environmental stress, the present civilization is facing high challenges for sustaining soil fertility, mitigating water demand and achieving optimum agricultural production (Mariya et al. 2019). To alleviate these challenges, researchers are looking towards nanotechnology, an emerging field of science, to understand and regulate nutrient application in agriculture on a nanoscale (1–100 nm) coupled with developing nano-fertilizers for sustainable agriculture. Nanotechnology can facilitate great potential to modify fertilizer production with controlled nutrient composition, improve nutrient use efficiency, boost crop production (Elemike et al. 2019) and realize sustainable and precision agriculture (Mikula et al. 2020). Nanoparticles are highly absorbed within biological systems (Srivastav et al. 2016). Zinc is one of the most essential plant nutrients which plays a significant role in the production of chlorophyll, synthesis of enzyme, hormone, and protein, elongation of internodes, pollination, germination, stronger emergence, greater vigour, healthier root growth and higher yield potential of many crops (Singh et al. 2019; García-López et al. 2019). Zinc (Zn) deficiency has become a global concern and severe deficiencies have been reported from the soils of the Indian sub-continent, South Africa, and South America, resulting in a lower production of crops leading to malnutrition of human beings, particularly in women and children. Zinc deficiency problem is severe, in India and other developing countries of the world and thereby demands an urgent intervention for better Zn-concentration in the cereal crops. Engineered-zinc oxide nanoparticles (ZnONPs) are being used as a plant nutrient carrier in agriculture; however, their ill effects have also raised a global concern regarding the toxicity of these nanoparticles at higher levels (at 500 mg/L or more) on soil microbiome (Yadav et al. 2014), triggering the significance of their dose optimization and risk assessment studies in the future. Shen et al. (2015) reported varying toxicity impacts of ZnONPs on different soils in the order of acid soils > neutral soils > alkaline soils, which indicated a larger scope of application of ZnONPs in neutral to alkaline soils. Furthermore, there are a few literatures to date to address the ecotoxicological risks and adaptable safety measures on ZnONPs. The status of soil microbial biomass carbon (SMBC) and microbial population has been a valuable measure for soil fertility. Therefore, the impact of ZnONPs on soil ecology was also evaluated to develop a better understanding for implying ZnONPs in sustainable agriculture. ZnONPs have been used extensively in the industrial sectors for a long time; however, developing nano-fertilizers for increasing the fertilizer-use-efficiency in agriculture has hardly been practiced. Keeping in views the above facts, the present study aims to (i) prepare and characterize ZnONPs, (ii) evaluate ZnONPs for wheat response in comparison to conventional delivery of Zn, (iii) assess the impact of ZnONPs on SMBC and bacterial population, and (iv) study the efficacy of seed coating and foliar application of ZnONPs in terms of yield and quality parameters of wheat.
Material and methods
Synthesis and characterization of ZnONPs
ZnONPs were synthesized by the thermal precipitation technique as reported earlier by Hayat et al. (2011) and Singh et al. (2019). Sodium hydroxide (0.9 M NaOH) was poured into zinc nitrate hexahydrate [0.1 M Zn(NO3)2.6H2O, 98%] solution along with constant and vigorous stirring at the temperature of 55 °C till forming a white precipitate. To decrease the particle size, the sonication process was done at a higher amplitude (50–60%) for 30 min by adjusting the probe sonicator. Finally, the solution was dried in vacuum at 60 °C. The resulting mixture was centrifuged at 500 rpm for 20-min following a triple-washing with double distilled water (DDW). The precipitate was dried at room temperature (26 ± 1 °C) for 48 h and later calcined in an electric muffle furnace at 300 and 500 °C for 2 hours. Scanning electron microscopy (SEM ZEISS MA EVO-18) was used to determine the size and morphology of ZnONPs. Spectrophotometer (Shimadzu UV-1800) and Energy Dispersive Analysis of X-rays (EDAX) were used for the determination of zinc composition, and Dynamic Light Scattering (DLS, Malvern Nano S 90) was used for the measurement of particle size distribution.
Preparation of suspension of ZnONPs and their application
ZnONPs were first prepared by using the combination of small (70%) and large (30%) size nanoparticles with the help of a mechanical stirrer. The dispersed ZnONPs were ultrasonicated using a 1-L conical flask containing 250 mL solution of ZnONPs placed on an ultrasonic bath at 100 W 40 kHz (Fisher Scientific FS 30H) for 30 min to agitate the solution and avoid cluster formation. To stabilize the suspension of ZnONPs, polyethylene glycol (PEG-400, 10% v/v) was added (Tshabalala et al. 2012). Then the solution was suspended and dispersed in DDW. The solution of zinc sulphate was also prepared in DDW using zinc sulphate heptahydrate (ZnSO4.7H2O) solution. Polydispersity index or PDI was used to estimate the uniformity of the ZnONPs. The value of PDI ranges from 0.0 (very uniform) to 1.0 (highly polydispersed sample). PDI is presently known as Dispersivity (Đ) which is calculated as follows:
PDI = Mw/Mn, where Mw is weight average molecular weight and Mn is number average molecular weight.
Experimental design
Several experiments were conducted for the improvement in Zn-delivery to wheat for sustainable production. Soil application of the conventional ZnSO4.7H2O was done at 10 mg/kg and ZnONPs at 2.5, 5, and 10 mg/kg. Seed priming was done in an aqueous nutrient solution with equal concentrations of both ZnSO4.7H2O and ZnONPs (at 100, 200, and 1000 mg/L). Foliar application with ZnSO4.7H2O at 0.5% and ZnONPs at 100, 200, and 500 mg/L was done. Basal doses of 50% N, 100% P2O5, and 100% K2O were applied at 60, 50, and 50 kg/ha using urea, di-ammonium phosphate (DAP), and muriate of potash (MOP) before sowing. The remaining 50% of N was applied through the foliar application of urea. Basal doses of Cu, Mn, and Fe, at 2.5, 5, and 10 mg/kg, respectively, were applied through their AR grade salts and were thoroughly mixed before sowing of the seeds. The details regarding the seed germination experiment, pot-culture experiment, micro-plot experiment, and multi-location field trials conducted during 2016–17 and 2017–18 are mentioned below.
Seed germination experiment
A laboratory experiment was conducted using wheat seeds of the variety ‘HD 3086’ (Pusa Gautami) which were procured from the Indian Agricultural Research Institute, Pusa, New Delhi having a maturity period of 143 days. Uniform sizes of seeds were selected to minimize the experimental errors. The seeds were soaked in the suspensions of ZnONPs and conventional ZnSO4.7H2O at different concentrations (100, 200, and 1000 mg/L) and duration (1, 2, and 3 days). The treatments were replicated thrice. The seeds were air-dried in shade for 1 h and then taken into a Petri dish (100 × 15 square millimeter) with the help of a sterilized filter paper and 5 mL of DDW as per the method of the International Seed Testing Association (Tekrony 2003). Then the samples or the Petri dishes were incubated at 26 ± 1 °C for 8 days. Enough moisture was maintained in the Petri plates through watering. Most seeds germinated after 8 days and the seedlings emerged and developed. The germination was calculated as a percentage. Seedling Vigour Index (SVI) was determined using the following formula (Abdul-Baki and Anderson 1973).
SVI = Germination % × (root length + shoot length).
Pot-culture experiments
Wheat seeds of variety ‘HD 3086’ were sown at the Amity Experimental Farm in earthen pots filled with 4 kg of Zn deficient soil having pH 7.8, electrical conductivity (EC) 0.40 dS/m, and organic carbon (OC) (0.49%). The experiments were designed under completely randomized block design (CRD) and each treatment was replicated thrice. The pots were watered to field capacity during rabi seasons of 2016–17 and 2017–18. Proper care was taken to use the same soil in all the pots to minimize soil heterogeneity effects. After germination, thinning was done and four plants per pot were maintained up to harvest. The treatments of the experiment were taken as (i) Control (no zinc), (ii) Soil application of ZnSO4.7H2O at 10 mg/kg (Gupta, 2015), (iii) Soil application of ZnONPs at 2.5, 5, and 10 mg/kg, seed priming of ZnSO4.7H2O and ZnONPs at 100, 200, 1000 mg/L, and foliar application of ZnSO4.7H2O at 0.5%, and ZnONPs at 100, 500, and 1000 mg/L.
Micro-plot experiments
Micro-plot experiments were conducted at the Amity Experimental Farm to study the effects of the conventional ZnSO4.7H2O and nano zinc oxide fertilizer on yield and yield attributes of wheat (Tritium aestivum L.) variety HD 3086. The experiments were conducted during rabi seasons of 2016–2017 and 2017–18 with three replications having 5 different treatments i.e., control (no Zn), foliar applications of ZnSO4.7H2O at 0.5% (recommended dose- Ministry of Agriculture, Govt. of India) (Gupta, 2015) and ZnONPs at 100, 500, and 1000 mg/L.
Field experiments
Field experiments on wheat were carried out at four different locations: (i) Village Manjhawli, District Faridabad, Haryana, (ii) Village Bohar, District Rohtak, Haryana, (iii) Village Dadri, District GB Nagar, Uttar Pradesh, and (iv) Village Aurangabad, District Bulandshahr, Uttar Pradesh. The wheat crop was established through a conventional method. The basal application of fertilizer DAP was applied at the rate of 125 kg/ha and the remaining nitrogen was applied through urea at 81.52 kg/ha at the time of sowing. For foliar application, urea was applied in two splits through manual top dressing, at the rate of 75 and 60 kg/ha during the first and second irrigations, respectively. Other agronomic practices were followed as per local standard recommendations for the wheat crop. The field experiments were laid out in a CRD in triplicates with four treatments. Each replicate was established in a 1-m square area. The soil application of Zn was done using ZnSO4.7H2O at 10 mg/kg (~ 2 g/m2 or 20 kg/ha) and synthesized ZnONPs at 2.5, 5, and 10 mg/kg (~ 0.5, 1.0, and 2.0 g/m2 or 5, 10, and 20 kg/ha, respectively). Foliar sprays of ZnSO4.7H2O at 0.5% and ZnONPs at 100, 200, and 1000 mg/L were done at flowering and milking stages, respectively. On foliar application, nanomaterials can enter the plant cells through the opening on leaves and aerial stem tissues such as stomata, hydathodes, lenticels, and other pores (Hong et al. 2016). Foliar spray of the dissolved Zn fertilizers at a rate of 600–700 L water per hectare was applied during shade or evening hours until leaves were moistened as described by Cakmak, (2008).
Plant analysis
Root length, shoot length, and plant biomass
Root length (in cm) was measured from the root tip to shoot base at 60 days after sowing (DAS). Shoot length (in cm) was measured from the shoot base to the shoot tip. At maturity, wheat was harvested, the plants were thoroughly cleaned from soil particles and the fresh weight was recorded using a digital weighing balance and was expressed as fresh biomass in gram/pot. After incubation, the plants were dried to a constant weight at 65 °C in a hot air oven until moisture escaped, the dried plant samples were weighed, averaged, and expressed as dry biomass in gram/pot.
Chlorophyll content
Total chlorophyll was estimated in wheat leaves at 60 DAS of the crop by Dimethyl sulphoxide (DMSO) extraction method. Leaf samples were procured randomly for each treatment and washed thoroughly. The leaf sample (0.1 g) was weighed and cut into small pieces. DMSO (7 ml) was measured in test tubes, the cut leaves were added to it, and put in a water bath for 30 min maintained at a temperature of 60 °C. The contents were filtered once the test tubes were cooled to room temperature and the DMSO was added to make the final volume 10 ml. The absorbance was recorded at 645 and 663 nm using a UV–vis. Spectrophotometer. Total chlorophyll (a + b) was determined using the following equation as proposed by Arnon (1949).
Total Chlorophyll (mg/g) = 20.2 (A645) + 8.02 (A663).
Zinc concentration
Post-harvest plant samples were washed thoroughly with the distilled water and dried to a constant weight in an oven at a temperature of 65 °C. The samples of grain were dried, ground, and 1 g of the sample was mixed with a di-acid mixture (HNO3 and HClO4 in 4:1 ratio) in a 100-mL conical flask and kept overnight for pre-digestion (Singh et al. 2005). The sample was digested on a hot plate between 150 and 290 °C and filtered. Then the volume was made up to 100 ml by the addition of DDW. Zinc concentrations were measured spectrophotometrically by using the Atomic Absorption Spectrophotometer (AAS; Analytik Jena, Model NovAA 350, Germany).
Soil analysis
Initial composite surface soil samples were taken using soil core samplers having the dimension of 5 cm-diameter and 15 cm-height from the selected villages: Bohar, Manjhawli, Aurangabad, and Kot representing rice–wheat growing areas of Haryana and Uttar Pradesh states. The samples were kept in a freezer and the moistened soil samples were used for the determination of SMBC. Soil samples were air-dried in the shade, ground, and sieved through passing a 2-mm size for the determination of their physicochemical characteristics (Singh et al. 2005), available P and K (Singh et al. 2005), and the di-ethylenetriamine-penta-acetic acid (DTPA)-extractable micronutrients (Kumar and Mani 2010). Initial soil pH in 1:2 soil: water suspension varied from 7.23 to 8.70 and EC ranged from 0.21–0.41 dS/m. The soils were alkaline and low in soluble salts with Walkley–Black OC content varying from 0.45 to 0.57 percent. Olsen’s–extractable P and NH4OAc–extractable K ranged from 7 to 11 kg/ha and 151 to 321 kg/ha, respectively. DTPA-extractable Zn in these soils varied from 0.47 to 0.85 mg/kg reflecting low to medium Zn status in these soils. These physicochemical parameters along with DTPA-extractable Fe, Cu, and Mn values are presented in Table 1.
Impact on soil microbial community
A preliminary study to determine the effect of ZnONPs on soil microorganisms was conducted as it is necessary for ecosystem functioning. Six different media, namely Nutrient Agar (Seeley et al. 1991), Potato Dextrose Agar (Waksman 1922), King's Agar B (King et al. 1954), Jensen’s Medium (Jensen 1942), Pikovskaya’s Agar (Pikovskaya 1948), and Kenknight Medium (Bailey et al. 2007) were used for recording population count of total bacteria, fungi, fluorescent Pseudomonas spp., nitrogen-fixing bacteria, phosphate solubilizing bacteria, and actinomycetes, respectively. The media were prepared according to standard protocol. Post-harvest soil samples were collected for control (no ZnONPs) and ZnONP (5 mg/kg) treated soil from a depth of 15 cm using a 5 cm-diameter tube auger and bulked. The moist soil samples were sieved using a 2-mm sieve. After removing the roots and plant materials, the soil was air-dried and stored at room temperature. Serial dilution plate count method was used for estimating colony-forming unit (CFU). One-gram soil was taken from control and ZnONPs-treated soils and then serial diluted to 10–6. Then 100 µl of the solution was poured onto each Petri plate containing different media and replicated thrice. The plates were kept in an incubator maintained at 28 °C for 4 days. The CFU for each plate was then determined and recorded.
Soil microbial biomass carbon
The SMBC was determined by the substrate-induced respiration method (Bailey et al. 2007; Yadav et al. 2014) by using gas chromatography (Agilent Model GC-4890). The oven-dry soil sample (10 g) was moistened with glucose solution (0.5 ml, 12 g L−1) and incubated for 3 h at 22 °C. The SMBC was calculated using the following formula:
where X = microbial biomass carbon (mg/kg) and Y = rate of CO2 evolution (ml CO2 kg−1 soil h−1).
Bacterial population
The bacteria in soil samples were counted using a standard soil dilution method as described by Chhonkar et al. (2007). The oven-dried soil samples (10 g) were homogenized in 90 ml double-distilled water using a blender for 15 min. The stock solution was diluted tenfold and the culture media plates were inoculated by using the spread plate technique. The inoculated Petri plates were inverted and incubated for 2–3 days. The CFUs were counted on the plate and calculated per gram of the dry-weight soil.
Statistical analysis
The Analysis of Variance (ANOVA) table was prepared to determine means, standard error (SE), and the level of significance among the different treatments, rows, and columns. Soil and plant data were replicated thrice and represented as mean ± SD values. The data obtained from the selected five locations were arranged in the Least Square Design (5 × 5 LSD with 5-replications) experiments for statistical conclusions and the F test values were compared for statistical significance. The probability values p < 0.05, p < 0.01, and p < 0.001 were taken as statistically significant, moderately significant, and highly significant, respectively. The GraphPad Prism version 9.0.2 was used for drawing figures representing three replications and standard deviation.
Results and discussion
Characteristics of the synthesized ZnONPs
The SEM images showed that the nanoparticles were spherical with a size range of 30–85 nm (Fig. 1a). However, the mean nanoparticle size was 36.7 nm as per the histogram of the number distribution curve. The EDX-spectra showed an elemental composition of 63.74% Zn (Fig. 1b). The Dynamic Light Scattering (DLS) technique confirmed the mean particle size of ZnONPs to 36.7 nm (Fig. 1c) ranging from 30 to 85 nm. Alamdari et al. (2020) and Aditya et al. (2018) reported the average particle size of ZnONPs ranging 60–65 nm through the DLS technique and TEM, respectively. However, Pavithra et al. (2017) reported the synthesis of spherical particles of ZnONPs having a size ranging from 20 to 50 nm while using an aqueous green leaf extract of Tabernaemontana divaricate green. Polydispersity index or PDI was calculated as 0.206 that indicated a high monodispersity of the nanoparticles, as the values around 0.1 are considered good or uniform for a monomodal dispersion and conversely the values around 0.7 are considered not uniform. Aditya et al. (2018) also observed an almost similar value of PDI around 0.2 during the characterization of ZnONPs in ionic liquids from 0 to 2 h period. A UV-absorption spectrum of ZnONPs (Fig. 1d) showed that the peak of the excitation band was observed at 374 nm which corresponds to the ZnONPs. An almost similar peak was observed at 376 nm by Alamdari et al. (2020) in the absorption spectrum of the biosynthesized ZnONPs.
a The SEM micrograph obtained at Amity University, Noida (EHT = 20.00 kV, WD = 7 mm, Mag = 55.0 kx, Model: SEM ZEISS MA EVO-18) b EDAX spectra showing Zn-composition c DLS graph showing the particle size of zinc oxide nanoparticles (ZnONPs), and d UV–Vis. spectra of the synthesized ZnONPs showing the peak of the excitation band at 374 nm
Wheat response to ZnONPs and ZnSO4.7H2O
The different levels of ZnONPs and ZnSO4.7H2O showed different responses on the germination of seeds and shoot elongation in wheat. The maximum seed germination percentage was 87.33% and the maximum seedling vigour index was 776.0 under the treatment of ZnONPs at 200 mg/L (Fig. 2a, b) which was observed higher than that of control and ZnSO4.7H2O (at 200 mg/L). The application of 200 mg/L ZnONPs increased wheat germination by 43.4% corresponding to ZnSO4.7H2O. Similarly shoot elongation, emergence, and vigour index were observed up to the maximum in 200 mg/L ZnONP treatment which could be attributed to enhanced production of auxins, responsible for shoot elongation and emergence. Treatment with ZnONPs results in strong emergence of seeds as compared to the conventional treatment with ZnSO4.7H2O, indicating that ZnONPs are easily absorbed by the wheat seeds to a larger extent, unlike ZnSO4.7H2O. However, the lower levels (100 and 200 mg/L) of ZnONPs were found to be more beneficial for the growth of wheat seedlings than the higher levels (400–1000 mg/L). The study revealed negative or inhibitory effects of ZnONPs at higher concentrations causing lesser shoot emergence and seedling vigour index as compared to the conventional ZnSO4.7H2O. The result indicates enhanced growth parameters of wheat crops when treated with ZnONPs applied (in mg/L) to the soil at 5, seed coating at 200, and foliar application at 100 as compared to control and bulk ZnSO4.7H2O (Fig. 3a, b, c). At higher concentrations, an inhibitory effect on the root, shoot growth, straw, and grain yield was observed. These results are in line with the observations of the laboratory experiments. Soil application of ZnONPs at 5 mg/kg gave better results over bulk ZnSO4.7H2O at 10 mg/kg and control or no zinc (Fig. 4). In 2016–17, even with a reduced dose of ZnONPs (5 mg/kg), improvement in root length was observed over control (33%) and bulk ZnSO4.7H2O (8.82%), whereas, in case of shoot growth, the figures obtained were 17.0% and 3.53%, respectively (Fig. 4a, 4b). Sabir et al. (2020) corroborated this finding to observe a significant increase in shoot length, root length, and protein content of Zea mays L by the application of biosynthesized ZnONPs at 8 mg/L. The total chlorophyll content of wheat leaves also showed improvement over control (12.56%) and normal ZnSO4.7H2O (5.60%) (Fig. 4c). Furthermore, straw yield increments over control and bulk ZnSO4.7H2O were 20.95% and 2.36%, respectively (Fig. 4d). Subsequently, there observed an improvement in grain yield over bulk ZnSO4.7H2O (2.27%) and control (9.76%) upon soil application of ZnONPs (Fig. 4e). Grain zinc concentration also slightly increased on the application of ZnONPs over control (6.05%) and bulk ZnSO4.7H2O (2.05%) (Fig. 4f). Almost a similar response on the yield and quality parameters of wheat was observed during the rabi season of 2017–18 (Fig. 4). Root elongation increased 29.60% and 4.30%, shoot elongation 15.05% and 3.99%, total chlorophyll 11.01% and 4.86% over control and bulk ZnSO4.7H2O, respectively. Similarly, straw yield increased by 22.24% and 2.44%, grain yield 10.2% and 1.7%, and grain zinc concentration 6.11% and 1.85% upon the soil application of ZnONPs over control and bulk ZnSO4.7H2O, respectively. Elemike et al. (2019) established the role of nanotechnology in the fortification of plant nutrients and the improvement of crop production. García-López et al. (2019) also observed a higher response of ZnONPs on chlorophyll and other bioactive compounds in pepper. Awasthi et al. (2017) observed a positive response of ZnONPs at 50 mg/L on seed germination, root and shoot growth, and biomass of wheat. Mazumder et al. (2020) recorded an increase in germination, grain yield, and dry biomass of wheat, lettuce, and mustard at lower levels (up to 50 mg/L) of ZnONPs; however, they observed reduced growth and yield parameters as well as genotoxic effects at higher levels (above 200 mg/L) of ZnONPs in different crops.
Different concentrations of bulk ZnSO4.7H2O and ZnONPs showing wheat response a seed germination and b seed vigor index; Application of ZnONPs at 100 and 200 mg/L is showing a higher response in comparison to control and conventional ZnSO4.7H2O. Each bar represents three replications along with standard deviation
In 2016–17, seed coating of ZnONPs (200 mg/L) had positive impacts on root length (7.09%), shoot length (3.55%), total chlorophyll (1.10%, NS), straw yield (2.23%), grain yield (1.63%, NS), and grain Zn concentration (0.76%), whereas in 2017–18, the values were 5.98% (root length), 4.03% (shoot length), 1.44% (total chlorophyll, NS), 2.76% (straw yield), 2.78% (grain yield), and 1.07% (grain Zn concentration) (Fig. 5). The study also reveals that yield and quality parameters also get marginalized at 200 mg/L seed coating and the dosage of seed coating should not be increased over 200 mg/L of ZnONPs. During 2016–18, foliar sprays of ZnONPs in rabi seasons showed improvement in root length of 10.08–12.01% over control and 1.74–2.11% over bulk ZnSO4.7H2O (Fig. 6a). Shoot length increased by 6.13–6.63% over control and 0.35–0.57% over bulk ZnSO4.7H2O (Fig. 6b). Sabir et al. (2020) reported a significant increase in shoot length, root length, and protein content of Zea mays L by the application of biosynthesized ZnONPs. Total chlorophyll also increased by 3.85–4.57% and 0.55–1.61%, respectively, over control and bulk ZnSO4.7H2O (Fig. 6c). Grain and straw yield increased by 4.88–5.56% and 9.50–14.42% over control, and 0.88–2.38% and 1.63–2.48% over bulk ZnSO4.7H2O, respectively (Fig. 6d, e). Zn concentration in the grain of wheat increased significantly with the foliar application of ZnONPs over control (81.55–85.14%) and bulk ZnSO4.7H2O (19.73–20.71%) (Fig. 6f). At higher foliar concentrations (> 100 mg/L), ZnONPs showed inhibitory effects on the growth and yield of wheat. The concentration of ZnONPs played a pivotal role in determining the growth of roots, shoots, and yield of wheat (Awasthi et al. 2017; Gomez et al. 2021). Lin and Xing (2008) observed that ZnONPs highly adhered to the root surface. Therefore, it may be concluded from the results that the application of nanoscale zinc fertilizers like ZnONPs in the right dose and at the right time is beneficial in improving the growth, yield, and grain Zn concentration of wheat as compared to conventional Zn fertilizer sources. In micro-plot experiments, the foliar application of ZnONPs (100 mg/L) on wheat increased grain yield over control (5.05%) and bulk ZnSO4.7H2O (0.60%) (Fig. 7a), whereas for grain Zn concentration, the figures were 90.33 and 19.98%, respectively (Fig. 7b). In 2016–17, the highest accumulation of Zn in grain (42.94 mg/kg) was recorded at 100 mg/L ZnONPs with an overall increase of 84.07 and 19.17% over control and bulk ZnSO4.7H2O, respectively (Fig. 8). Similarly, in 2017–18, the highest grain Zn concentration (44.71 mg/kg) was observed on the foliar application of ZnONPs at100 mg/L with an increase of 83.19 and 17.85% over control and ZnSO4.7H2O, respectively (Fig. 8). Under field conditions, even with 11 times reduction in zinc dose, i.e. 100 mg/L of ZnONPs, grain yield and grain Zn concentration of wheat were increased in comparison to the conventional ZnSO4.7H2O. The higher accumulation of Zn in the wheat grain due to the foliar application may be attributed to the enhanced translocation of Zn into grains as compared to the conventional ZnSO4.7H2O. Similarly, Dapkekar et al. (2018) and Poornima and Koti (2019) reported higher grain zinc content in wheat and sorghum by the application of Zinc-complexed chitosan nanoparticles and ZnONPs, respectively. Recently, Doolette et al. (2020) observed a higher and significant translocation of Zn to wheat grain by the foliar application of ZnONPs in comparison to the conventional foliar fertilizer applications. Overall, the present results depicted a higher response of ZnONPs over the conventional ZnSO4.7H2O. Germination percentage, root and shoot length, chlorophyll content, grain yield, straw yield, and Zn concentration were improved due to the application ZnO at nanoscale in pot culture experiments as well as in micro-plot and field experiments over the conventional ZnSO4.7H2O and control. In the present study, it was observed that a lower concentration (100 mg/L) of ZnONPs shows a positive effect while higher concentrations showed an inhibitory effect on wheat crop growth and development (Awasthi et al. 2017). The current study reveals that nanofertilizer is one of the best alternatives to chemical fertilizers to mitigate the nutrient deficiency in soils and improve fertilizer use efficiency by providing sustained release of Zn to wheat crops (Dapkekar et al. 2018, 2020; Gomez et al. 2021) for sustainable crop production. The present study suggests decreasing the Zinc application rate in wheat through the application of ZnONPs at 100 mg/L. The size, morphology, and surface area of nanofertilizers play a crucial role in the bioavailability of their nutrient components from soils to plants. In addition, nanofertilizer can be further engineered for the specific nutrient requirement of a particular soil or plant (Elemike et al. 2019; Iqbal 2019) by conducting specific field and greenhouse experiments to minimize the risk of environmental pollution.
Soil fertility status
The data regarding post-harvest soil samples analysis showed that the pH of soil varied from 7.4 to 8.75, EC 0.25 to 0.32 dS m−1, and OC 0.40 to 0.50%. Values of available P and K (in kg/ha) were in the range of 6–10 and 139–310, respectively (Table 1) at pre-harvest stage. The post-harvest values of DTPA-extractable Zn, Fe, Cu, and Mn are presented in Table 2. The DTPA-extractable Zn content along with other micronutrients (DTPA-extractable Fe, Mn, and Cu) declined from the initial levels in the farmers’ fields of all the four selected sites (Rohtak, Faridabad, Bulandshahr, and G.B. Nagar) as a result of multiple cropping (Tables 1, 2). A continuous decline in the levels of micronutrients from the farmers’ fields demands an alternative approach against the conventional system to mitigate the micronutrient supply to wheat crops and ultimately sustain its productivity. In the present study, Zn-concentration in grains of wheat significantly increased at the application of 100 mg/L of ZnONPs to all these selected sites (Fig. 8) which might be ascribed to increased water absorption and retention capacities of nanoparticles (Tarafder et al. 2020). Similarly, other micronutrient concentrations can be improved in agricultural soils and plants by the controlled application of nanoparticles. Recently, Tarafder et al. (2020) formulated a hybrid nanofertilizer (HNF), comprising of Cu, Fe, and Zn nanofertilizers incorporated into urea hydroxyapatite, for slow and sustainable release of these micronutrients into soils. Mazumder et al. (2020) recommended ZnONPs in several crops like wheat, soybean, beans, Lettuce, and mustard as a replacement for conventional and harmful chemical fertilizers. Similar to the present study, Yusefi-Tanha et al. (2020) did not report any adverse effect of ZnONPs up to 160 mg/kg in zinc-deficient soils to improve soybean yield and its food quality. Thus, the application of zinc nanofertilizer is not only essential for sustainable wheat production but also can address malnutrition in several developing countries globally.
Soil microbial biomass carbon
Among five treatments, the SMBC was maximum at 100 mg/L ZnONPs to the extent of 321 mg/kg which was found higher than that of 0.5% ZnSO4.7H2O (308.2 mg/kg) treatment. However, the SMBC was observed higher at the stem elongation stage than the tillering stage of wheat under all treatments except in the treatment of ZnONPs at 500 mg/L. The study reveals a sharp decline in the SMBC contents when the dosage of ZnONPs increased from 200 to 500 mg/L (Table 3). Thus, 100 mg/L ZnONPs as a dose was optimized for the foliar application in wheat. The study reveals that SMBC is influenced by the applied ZnONPs at 100 mg/L to supply the micronutrient Zn2+ at an optimum level to promote growth and increase the biomass of soil microbes. Jiang et al. (2020) observed a significant increase in the levels of SMBC by the application of ZnONPs at 100 mg/kg in soils. In line with the present findings, Rashid et al. (2017) observed a significant decline in the levels of SMBC by the application of ZnONPs at 1000 mg/kg. Thus, a change in the levels of SMBC is dose-dependent as well as plant growth stage-dependent in case of the application of ZnONPs to produce wheat. The present study reveals that foliar application of ZnONPs at an optimized dose (up to 100 mg/L) can cause a beneficial impact on SMBC. Seyed-Sharifi et al. (2020) recorded an improved yield of wheat under drought stress conditions by the combined application of Azotobacter (biofertilizer) and nano Zn-Fe oxides (nanofertilizer).
Bacterial population
Among five treatments, the bacterial count was maximum at 100 mg/L ZnONPs to the extent of 25.8 × 106 which was found higher than that of 0.5% ZnSO4.7H2O (308.2 mg/kg) treatment. However, the bacterial count was observed higher at the stem elongation stage than the tillering stage of the wheat under all treatments except in the treatment ZnONPs at 500 mg/L. The study reveals a sharp decline in the bacterial population when the dosage of ZnONPs increased from 200 to 500 mg/L (Table 4). Foliar application of ZnONPs at 100 mg/L resulted in an enrichment of SMBC and build-up of soil bacterial population; however, a higher dosage (> 200 mg/L) negatively affected these values which may be attributed to the antibacterial activity of ZnONPs at higher concentrations. Ishwarya et al. (2018) found the antibacterial activity of ZnONPs against Staphylococcus aureus, Streptococcus mutans, Vibrio cholerae, Neisseria gonorrhoeae, Klebsiella pneumonia, and antifungal activity against Aspergillus niger, and Candida sp. Aditya et al. (2018) also observed the antimicrobial activity of ZnONPs against Escherichia coli, Bacillus subtilis, Staphylococcus aureus, Klebsiella pneumonia, and Staphylococcus epidermidis at higher levels. Nibin et al. (2019) recorded the maximum bacterial count, dehydrogenase, urease, and acid phosphatase by the combined application of nano NPK (12.5 kg/ha), foliar application of nano NPK (0.4%), and FYM (12 t/ha) in the post-harvest status of the soil. The present study reveals a dose-dependent response of ZnONPs which can boost the bacterial population at 100 mg/L.
Conclusions
The results of the present study indicated that the delivery of Zn nutrient through nanoscale ZnO fertilizer improved the Zn content significantly in grains of wheat thereby improving agronomic biofortification. Zn-delivery through nanoscale ZnO fertilizers at 100–200 mg/L resulted in an improvement in germination rate, root and shoot elongation, seedling vigour index, chlorophyll content, grain Zn-concentration, and grain yield of wheat. The application of Zn-nanofertilizer at 100 mg/L improves fertilizer use-efficiency in wheat as compared to conventional ZnSO4.7H2O. Even with an 11-times reduction in Zn dose as compared to conventional ZnSO4.7H2O, the use of ZnONPs as a foliar spray at particular stages of growth, i.e., tillering and stem elongation can increase the yield and plant capacity to take zinc and improve the use efficiency of nano zinc fertilizers. The application of nano zinc fertilizers can help to enhance the growth and yield of wheat crops, particularly in low zinc soils. However, higher doses of ZnONPs (> 200 mg/L) negatively influenced both plant growth and yield parameters. The delivery of Zn nutrient through ZnONPs at the right dose, at the right time, and of the right size could be effective and beneficial in enhancing the growth and yield attributes of wheat. The present research opens a new avenue of reducing the dose of Zn using nanostructured fertilizers like ZnONPs as compared to conventional ZnSO4.7H2O fertilizer. Nanofertilizers have a huge potential in the agriculture sector in improving crop growth, yield, and bio-fortifying food grains as supported by scientific findings from this study and several others. The use of nanofertilizers at an optimum dosage can reduce the input-cost and check environmental pollution by decreasing nutrient runoff due to the lower dose of application. The benefits of the use of nanoscale micronutrient fertilizers can ensure increased bioavailability, slow and controlled release of the micronutrients, longer lifetime, and reduced losses of nutrients in comparison to conventional fertilizers. Nanomaterials could be beneficial in designing more soluble and diffusible sources of zinc fertilizers which are capable of releasing nutrients in synchrony with crop demand for increased and sustained productivity. Zinc nanofertilizer is the future of precision agriculture in zinc-deficient soils. Thus, the present study reveals a new avenue in the field of sustainable agriculture to apply micronutrients and biofertilizers in soils on a nano-scale rather than conventional methods.
Significance of the work
Engineered Zinc oxide Nanopraticles (ZnONPs) can be used as a nanofertilizer and provides an alternative to soil based application of Zinc Sulphate. Application of ZnONPs to wheat crop increased their growth, yield and grain Zn-content (7.9–20%) as compared to the conventional zinc sulphate (ZnSO4.7H2O) at 0.5%. Further, application of the spherically synthesized ZnONPs (average size-36.7 nm) at 5 mg/kg in the soil application and 100 mg/L in the foliar application was found effective for sustainable wheat production in Zn-deficient neutral and alkaline soils. It is envisaged that targeted delivery of effective nanoscale Zn will lead to production of Zn enriched grains in Zn deficient soils.
References
Abdul-Baki AA, Anderson JD (1973) Vigor determination in soybean seed by multiple criteria. Crop Sci 13(6):630–633
Aditya A, Chattopadhyay S, Jha D, Gautam HK, Maiti S, Ganguli M (2018) Zinc oxide nanoparticles dispersed in ionic liquids show high antimicrobial efficacy to skin-specific bacteria. ACS Appl Mater Interfaces 10(18):15401–15411. https://doi.org/10.1021/acsami.8b01463
Alamdari S, Ghamsari MS, Lee C, Han W, Park HH, Tafreshi MJ, Afarideh H, Ara MHM (2020) Preparation and characterization of Zinc oxide nanoparticles using leaf extract of Sambucus ebulus. Appl Sci 10:3620. https://doi.org/10.3390/app10103620
Arnon DI (1949) Copper enzymes in isolated chloroplasts Polyphenoloxidase in Beta vulgaris. Plant Physiol 24(1):1–15
Awasthi A, Bansal S, Jangir LK, Awasthi G, Awasthi KK, Awasthi K (2017) Effect of ZnO nanoparticles on Germination of Triticum aestivum Seeds. Adv Soft Mater 376(1):1700043. https://doi.org/10.1002/masy.201700043
Bailey VL, Smith JL, Bolton H Jr (2007) Substrate-induced respiration and selective inhibition as measures of microbial activity in soils. In: Carter MR, Gregorich EG (eds) Soil sampling and methods of analysis. CRC Press, Boca Raton, p 30
Cakmak I (2008) Enrichment of cereal grains with zinc: agronomic or genetic biofortification? Plant Soil 302(1–2):1–17
Chhonkar PK, Bhadraray S, Patra AK, Purakayastha TJ (2007) Experiments in soil biology and biochemistry. Westville Publishing House, New Delhi
Dapkekar A, Deshpande P, Oak MD, Paknikar KM, Rajwade JM (2018) Zinc use efficiency is enhanced in wheat through nanofertilization. Sci Rep 8:6832. https://doi.org/10.1038/s41598-018-25247-5
Doolette CL, Read TL, Howell NR, Cresswell T, Lombi E (2020) Zinc from foliar-applied nanoparticle fertiliser is translocated to wheat grain: a 65Zn radiolabelled translocation study comparing conventional and novel foliar fertilisers. Sci Total Environ 749:142369. https://doi.org/10.1016/j.scitotenv.2020.142369
Elemike EE, Uzoh IM, Onwudiwe DC, Babalola OO (2019) The role of nanotechnology in the fortification of plant nutrients and improvement of crop production. Appl Sci 9:499. https://doi.org/10.3390/app9030499
García-López JI, Niño-Medina G, Olivares-Sáenz E, Lira-Saldivar RH, Barriga-Castro ED, Vázquez-Alvarado R, Rodríguez-Salinas PA, Zavala-García F (2019) Foliar application of Zinc oxide nanoparticles and Zinc sulfate boosts the content of bioactive compounds in Habanero peppers. Plants 8:254. https://doi.org/10.3390/plants8080254
Gomez A, Narayan M, Zhao L, Jia X, Bernal RA, Lopez-Moreno ML, Peralta-Videa JR (2021) Effects of nano-enabled agricultural strategies on food quality: current knowledge and future research needs. J Hazard Mater 401:123385. https://doi.org/10.1016/j.jhazmat.2020.123385
Gupta R (2015) Guidelines for use of micronutrients, soil ameliorants and integrated nutrient management practices in NFSM States. New Delhi: Ministry of Agriculture Government of India, pp 11–12. https://www.farmer.gov.in/imagedefault/handbooks/BooKLet/DELHI/20150515220851Micronutrient.pdf.
Hayat K, Gondal MA, Khaled MM, Ahmed S, Shemsi AM (2011) Nano ZnO synthesis by modified sol gel method and its application in heterogeneous photocatalytic removal of phenol from water. Appl Catal A 393(1–2):122–129
Hong J, Wang L, Sun Y, Zhao L, Niu G, Tan W, Rico CM, Peralta-Videa JR, Gardea-Torresdey JL (2016) Foliar applied nanoscale and microscale CeO2 and CuO alter cucumber (Cucumis sativus) fruit quality. Sci Total Environ 563:904–911
Iqbal MA (2019) Nano-fertilizers for sustainable crop production under changing climate: a global perspective. Sustainable crop production (Book Chapter). IntechOpen, Rijeka. https://doi.org/10.5772/intechopen.89089
Ishwarya R, Vaseeharan B, Kalyani S et al (2018) Facile green synthesis of zinc oxide nanoparticles using Ulva lactuca seaweed extract and evaluation of their photocatalytic, antibiofilm and insecticidal activity. J Photochem Photobiol B Biol 178:249–258
Jensen HL (1942) Nitrogen fixation in leguminous plants II: is symbiotic nitrogen fixation influenced by Azotobacter. Pro Line Soc NSW 57:205–212
Jiang H, Wang H, Yang B, Cao X, Liu X (2020) Effects of ZnO nanoparticles on microbial biomass and enzyme activity in soils containing cellulose and lignin. E3S Web Conf 194:5028. https://doi.org/10.1051/e3sconf/202019405028
King EO, Ward MK, Raney DE (1954) Two simple media for the demonstration of pyocyanin and Fuorescin. J Lab Clin Med 44:301–307
Kumar C, Mani D (2010) Enrichment and management of heavy metals in sewage irrigated soil. Academic Publishing AV Akademikerverlag GmbH and Co. KG, Germany, pp 1–123 (ISBN No. 978-3-8383-9893-8)
Lin D, Xing B (2008) Root uptake and phytotoxicity of ZnO nanoparticles. Environ Sci Technol 42(15):5580–5585
Mariya A, Kumar C, Masood M, Kumar N (2019) The pristine nature of river Ganges: its qualitative deterioration and suggestive restoration strategies. Environ Monit Assess 191:542. https://doi.org/10.1007/s10661-019-7625-7
Mazumder JA, Khan E, Perwez M, Gupta M, Kumar S, Raza K, Sardar M (2020) Exposure of biosynthesized nanoscale ZnO to Brassica juncea crop plant Morphological, biochemical, and molecular aspects. Sci Rep 10:8531. https://doi.org/10.1038/s41598-020-65271-y
Mikula K, Izydorczyk G, Skrzypczak D, Mironiuk M, Moustakas K, Witek-Krowiak A, Chojnacka K (2020) Controlled release micronutrient fertilizers for precision agriculture–A review. Sci Total Environ 712:136365. https://doi.org/10.1016/j.scitotenv.2019.136365
Nibin PM, Ushakumari K, Ishrath PK (2019) Organic nano NPK formulations on soil microbial and enzymatic activities on post harvest soil of Bhindi. Int J Curr Microbiol App Sci 8(4):1814–1819
Pavithra N, Lingaraju K, Raghu G, Nagaraju G (2017) Citrus maxima (pomelo) juice mediated eco-friendly synthesis of ZnO nanoparticles: applications to photocatalytic, electrochemical sensor and antibacterial activities. Spectrochim Acta A2017(185):11–19
Pikovskaya RI (1948) Mobilization of phosphorous in soil in connection with vital activity of some microbial species. Microbiologiya 17:362–370
Poornima R, Koti RV (2019) Effect of nano zinc oxide on growth, yield and grain zinc content of sorghum (Sorghum bicolor). J Pharmacogn Phytochem 8(4):727–731
Rashid MI, Shahzad T, Shahid M, Ismail IMI, Shah GM, Almeelbi T (2017) Zinc oxide nanoparticles affect carbon and nitrogen mineralization of Phoenix dactylifera leaf litter in a sandy soil. J Hazard Mater 324:298–305
Sabir S, Zahoor MA, Waseem M, Siddique MH, Shafique M, Imran M, Hayat S, Malik IR, Muzammil S (2020) Biosynthesis of ZnO nanoparticles using Bacillus subtilis: characterization and nutritive significance for promoting plant growth in Zea mays L. dose-response. Dose Response 18(3):155932582095891. https://doi.org/10.1177/1559325820958911
Seeley HW, Van De Mark PJ, Lee JJ (1991) Microbes in action: a laboratory manual of microbiology, 4th edn. W.H Freeman and Co., Gordonsville
Seyed-Sharifi R, Khalilzadeh R, Pirzad A, Anwar S (2020) Effects of biofertilizers and Nano Zinc-Iron oxide on yield and physicochemical properties of wheat under water deficit conditions. Commun Soil Sci Plant Anal 51(19):2511–2524
Shen Z, Chen Z, Hou Z, Li T, Lu X (2015) Ecotoxicological effect of zinc oxide nanoparticles on soil microorganisms. Front Env Sci Eng 9(5):912–918
Singh D, Chhonkar PK, Dwivedi BS (2005) Manual on soil, plant and water analysis. Westville Publishing House, New Delhi, p 200
Singh K, Madhusudanan M, Ramawat N (2019) Synthesis and characterization of zinc oxide nanoparticles (ZnONPs) and their effect on growth, Zn content and yield of rice (Oryza sativa L.). Journal of Multidisciplinary Engineering Science and Technology (JMEST), ISSN: 2458–9403 Vol. 6 Issue 3, www.jmest.org JMESTN42352879 9750
Srivastav AK, Kumar M, Ansari NG, Jain AK, Shankar J, Arjaria N, Jagdale P, Singh D (2016) A comprehensive toxicity study of zinc oxide nanoparticles versus their bulk in wistar rats: toxicity study of zinc oxide nanoparticles. Hum Exp Toxicol 35(12):1286–1304
Tarafder C, Daizy M, Alam MM, Ali MR, Islam MJ, Islam R, Ahommed MS, Aly MAS, Khan MZH (2020) Formulation of a hybrid Nanofertilizer for slow and sustainable release of micronutrients. ACS Omega 5(37):23960–23966
Tekrony DM (2003) Precision is an essential component in seed vigour testing. Seed Sci Technol 31(2):435–447
Tshabalala M, Dejene B, Swart H (2012) Synthesis and characterization of ZnO nanoparticles using polyethylene glycol (PEG). Phys B Condens Matter 407:1668–1671
Yadav RC, Patra AK, Purakayastha TJ, Singh R, Kumar C (2014) Effect of engineered nanoparticles of Fe and Zn oxides on enzyme activity and bacterial abundance in soil at ambient and elevated atmospheric CO2. Proc Natl Acad Sci India Sec B Biol Sci 84(3):649–656
Waksman SA (1922) A method for counting the number of fungi in the soil. J Bacteriol 7:339–341
Yusefi-Tanha E, Fallah S, Rostamnejadi A, Pokhrel LR (2020) Zinc oxide nanoparticles (ZnONPs) as a novel nanofertilizer: influence on seed yield and antioxidant defense system in soil grown soybean (Glycine max cv. Kowsar). Sci Total Environ 738:140240. https://doi.org/10.1016/j.scitotenv.2020.140240
Acknowledgements
The authors acknowledge the Department of Science and Technology (DST) for granting the project entitled “Improvement in zinc micronutrient delivery for cereal crops employing engineered nanoparticles” [DST File No. SR/NM/NS-1109/2015(G)]. They are also grateful to Dr. Jagriti Narang, Amity Institute of Nanotechnology, and Dr. Amit C. Kharkwal, Amity Institute of Technology, AUUP, for their valuable guidance and support.
Author information
Authors and Affiliations
Contributions
Kuldeep Singh (KS), Mukil Madhusudanan (MM), and Naleeni Ramawat (NR) designed and performed the work. KS, AKV, NR, and Chitranjan Kumar (CK) wrote the original manuscript after completion of a project work [DST File No. SR/NM/NS-1109/2015(G)]. KS, AKV, NR, and CK substantially revised and edited the manuscript.
Corresponding author
Ethics declarations
Conflict of interest
The corresponding author declares that there is no conflict of interest among all authors to publish this manuscript in this journal.
Supplementary Information
Below is the link to the electronic supplementary material.
Rights and permissions
About this article
Cite this article
Singh, K., Madhusudanan, M., Verma, A.K. et al. Engineered zinc oxide nanoparticles: an alternative to conventional zinc sulphate in neutral and alkaline soils for sustainable wheat production. 3 Biotech 11, 322 (2021). https://doi.org/10.1007/s13205-021-02861-1
Received:
Accepted:
Published:
DOI: https://doi.org/10.1007/s13205-021-02861-1